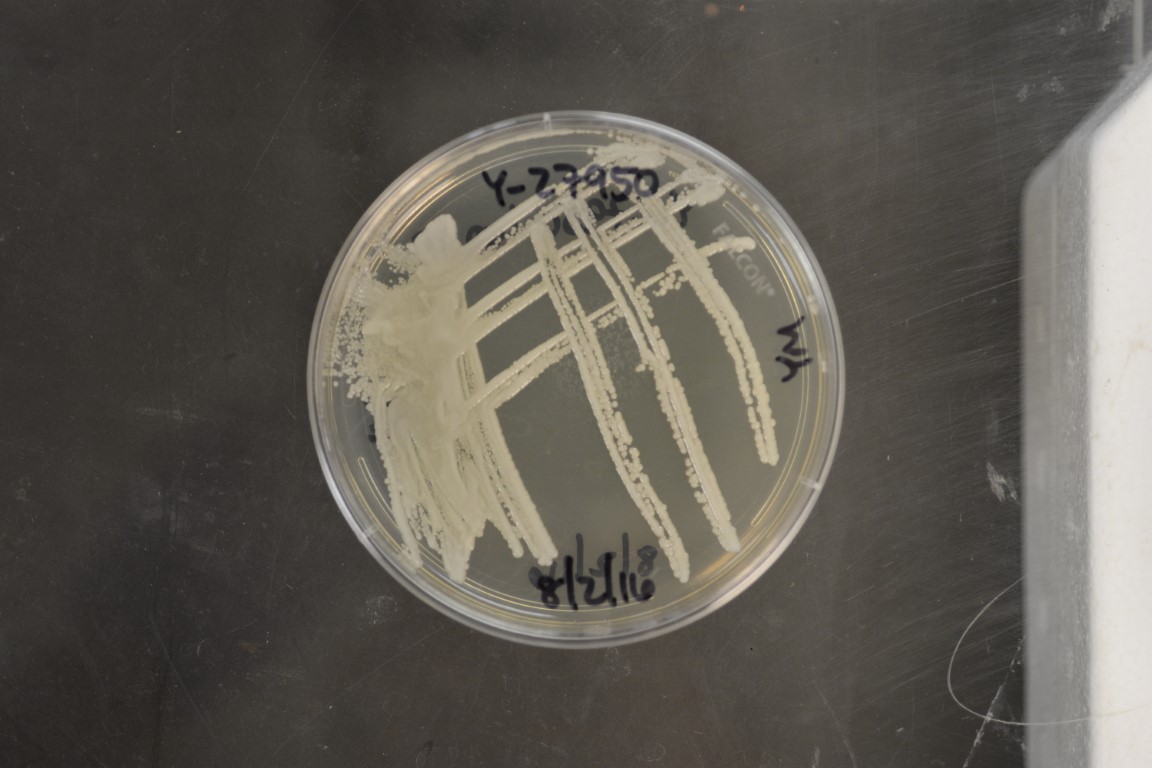

Candida dosseyi
NRRL Y-27950(Type Strain)
Accession numbers in other collections:CBS 10313=IY 05-6-6-2-4-2
Source:Sung-Oui Suh,Louisiana State University,Baton Rouge,Louisiana
Isolated from(substrate):IN,gut of female dobsonfly Corydalus cornutus(Neuroptera:Corydalidae)caught at light
Substrate location:Levy County,Gulf Hammock,Florida,USA
Genetic info:GenBank:SSU(DQ655699),LSU(DQ655681).
Growth media:Yeast Extract-Malt Extract-Peptone-Glucose(YM for yeasts)(number 6)
Optimum growth temperature:25C
Strain images:
NRRL_Y-27950_6.JPG

Comments:Mycologia 99,842-858(2007).